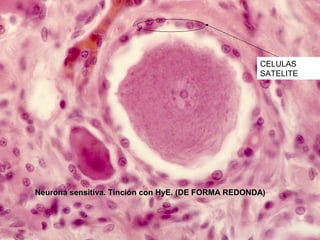
CELULAS
                                                    SATELITE




Neurona sensitiva. Tinción con HyE. (DE FORMA REDONDA)

Este documento proporciona información sobre el tejido nervioso. Resume las principales células del sistema nervioso como neuronas, astrocitos, oligodendrocitos y microglia. También describe la organización del tejido nervioso en el sistema nervioso central y periférico, incluidos los ganglios nerviosos, nervios y terminaciones nerviosas.